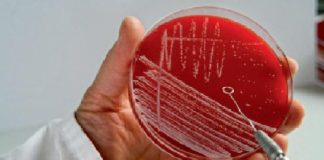
Antimicrobial resistance: Asia Pacific countries vow to tackle it together

Tag: Dr Poonam Khetrapal Singh
World Malaria Day: Sustained efforts needed to contain disease, advises WHO
World Health Organization has advised the South-East nations to work on the effective strategies to tackle Malaria...
Antimicrobial resistance: Asia Pacific countries vow to tackle it together
This high level ministerial meeting was held in Tokyo and organized by the Government of Japan and WHO...
Leave no one behind, make Universal Health Coverage a reality: WHO
As per the World Health Organization (WHO), the countries in the South East Asia need to take urgent...
World TB Day: Fast tracking access to quality diagnosis & treatment
Treatment success rates among new smear positive pulmonary TB cases have remained above 85% since 2005..
World Birth Defects Day: WHO urges SE Asian governments to improve...
As per Dr Poonam Khetrapal Singh, the WHO Regional Director for South-East Asia, creating awareness among the public...